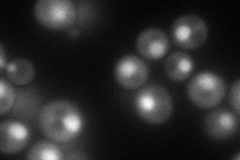
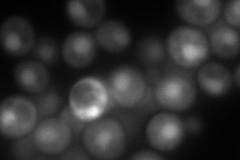
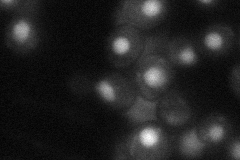
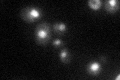

View description
Nuclear protein that binds to and stabilizes the exoribonuclease Rat1p, required for pre-rRNA processing
Localization:
Intensity:
Fold change:
Significance:
-
C’ GFP library in SD

nucleus43.86 -
N' NOP1pr-GFP in SD
nucleus98.5037 -
N' TEF2pr-mCherry in SD
nucleus134.086 -
N' NATIVEpr-GFP in SD
nucleus45.8717 -
N' TEF2pr-VC and Cyto-VN in SD

nucleus41.0124 -
C’ GFP library in SD+DTT

nucleus47.491.08No -
C’ GFP library in SD+H2O2

nucleus45.811.04No -
C’ GFP library in Starvation Media
nucleus52.021.18No -
C’ GFP library on the background of Pup2-DaMP

nucleus -
C’ GFP library on the background of CCT mutant

nucleus46.26251.05461No
